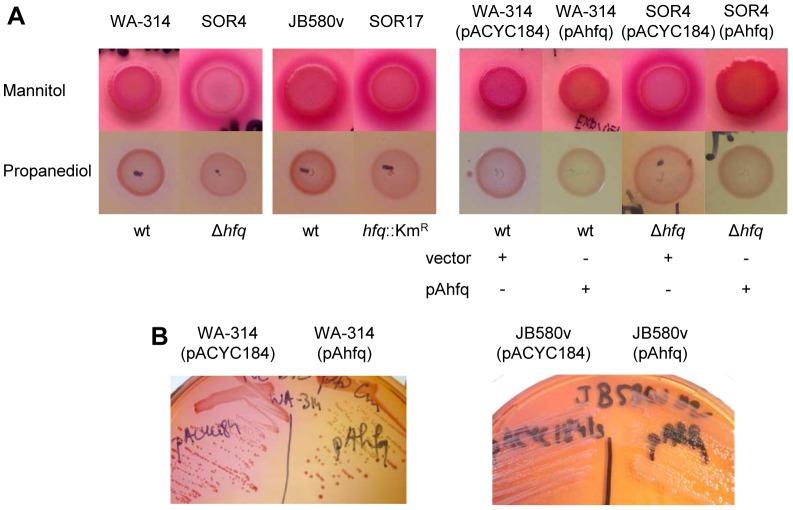

Hfq 等 RNA 伴侣蛋白影响肠侵袭性大肠杆菌的生长、代谢和毒力因子的产生。
The RNA chaperone Hfq impacts growth, metabolism and production of virulence factors in Yersinia enterocolitica.
机构信息
Max von Pettenkofer Institute for Hygiene and Medical Microbiology, Ludwig Maximilians University, Munich, Germany.
Protein Analysis Unit, Adolf-Butenandt Institute, Ludwig Maximilians University, Munich, Germany.
出版信息
PLoS One. 2014 Jan 15;9(1):e86113. doi: 10.1371/journal.pone.0086113. eCollection 2014.
To adapt to changes in environmental conditions, bacteria regulate their gene expression at the transcriptional but also at the post-transcriptional level, e.g. by small RNAs (sRNAs) which modulate mRNA stability and translation. The conserved RNA chaperone Hfq mediates the interaction of many sRNAs with their target mRNAs, thereby playing a global role in fine-tuning protein production. In this study, we investigated the significance of Hfq for the enteropathogen Yersina enterocolitica serotype O:8. Hfq facilitated optimal growth in complex and minimal media. Our comparative protein analysis of parental and hfq-negative strains suggested that Hfq promotes lipid metabolism and transport, cell redox homeostasis, mRNA translation and ATP synthesis, and negatively affects carbon and nitrogen metabolism, transport of siderophore and peptides and tRNA synthesis. Accordingly, biochemical tests indicated that Hfq represses ornithine decarboxylase activity, indole production and utilization of glucose, mannitol, inositol and 1,2-propanediol. Moreover, Hfq repressed production of the siderophore yersiniabactin and its outer membrane receptor FyuA. In contrast, hfq mutants exhibited reduced urease production. Finally, strains lacking hfq were more susceptible to acidic pH and oxidative stress. Unlike previous reports in other Gram-negative bacteria, Hfq was dispensable for type III secretion encoded by the virulence plasmid. Using a chromosomally encoded FLAG-tagged Hfq, we observed increased production of Hfq-FLAG in late exponential and stationary phases. Overall, Hfq has a profound effect on metabolism, resistance to stress and modulates the production of two virulence factors in Y. enterocolitica, namely urease and yersiniabactin.
为了适应环境条件的变化,细菌在转录水平以及转录后水平上调节其基因表达,例如通过小 RNA(sRNA)来调节 mRNA 的稳定性和翻译。保守的 RNA 伴侣 Hfq 介导许多 sRNA 与其靶 mRNA 的相互作用,从而在精细调节蛋白质产生方面发挥全局作用。在这项研究中,我们研究了 Hfq 对肠道病原体肠耶尔森氏菌 O:8 型的重要性。Hfq 促进了复杂和基础培养基中的最佳生长。我们对亲本和 hfq 阴性菌株的比较蛋白质分析表明,Hfq 促进脂质代谢和运输、细胞氧化还原稳态、mRNA 翻译和 ATP 合成,并且负调控碳和氮代谢、铁载体和肽的运输以及 tRNA 合成。相应地,生化测试表明 Hfq 抑制鸟氨酸脱羧酶活性、吲哚产生以及葡萄糖、甘露醇、肌醇和 1,2-丙二醇的利用。此外,Hfq 抑制铁载体耶尔森菌素及其外膜受体 FyuA 的产生。相反,hfq 突变体表现出降低的脲酶产生。最后,缺乏 hfq 的菌株对酸性 pH 和氧化应激更敏感。与其他革兰氏阴性菌的先前报道不同,Hfq 对于毒力质粒编码的 III 型分泌系统是可有可无的。使用染色体编码的 FLAG 标记的 Hfq,我们观察到在指数晚期和静止期 Hfq-FLAG 的产量增加。总的来说,Hfq 对代谢、应激抗性有深远影响,并调节了肠耶尔森氏菌中两种毒力因子的产生,即脲酶和耶尔森菌素。